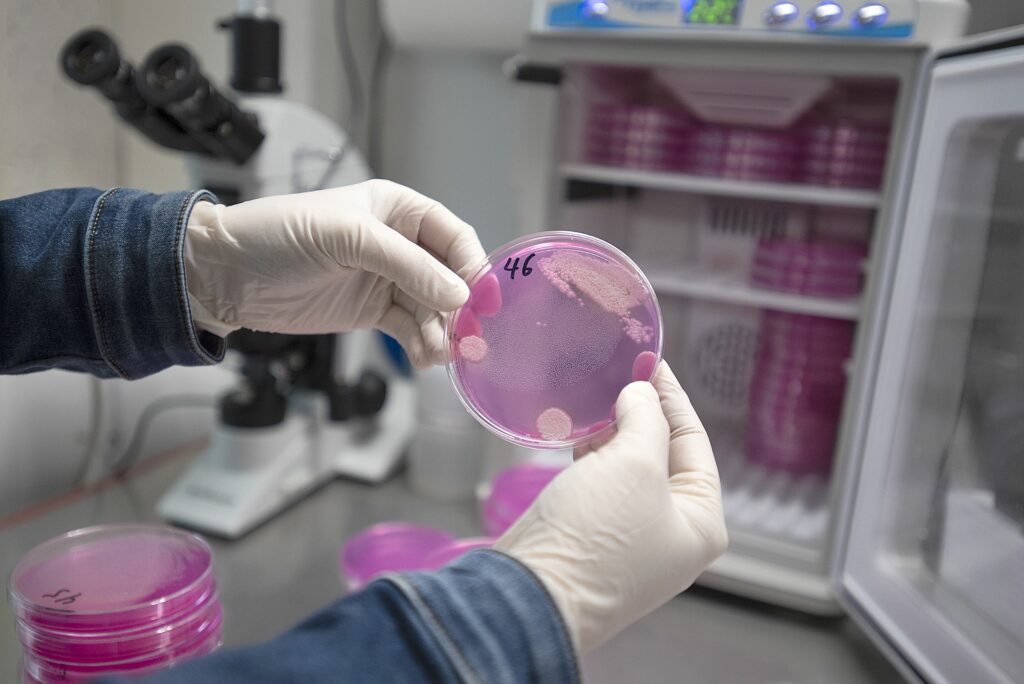
expertii-trag-un-semnal-de-alarma:-o-ciuperca-patogena-ar-putea-ucide-milioane-de-oameni

Corpul îmbătrânește rapid între 44 și 60 de ani. Obiceiuri care încetinesc îmbătrânirea

Experții susțin că aceste obiceiuri trebuie adoptate înainte de 44 de ani. Cercetătorii de la Stanford au studiat 108 participanți cu vârste între 25 și 75 de ani. Ei au descoperit că moleculele nu se modifică liniar în timp, ci în valuri. Schimbările dramatice apar în jurul vârstei de 44 și 60 de ani. „Se pare că vârsta de 40 de ani este o perioadă de schimbări dramatice, la fel ca și începutul anilor 60″, a spus Michael Snyder, profesor de genetică la Stanford. Obiceiuri sănătoase înainte de 44 de ani Experții recomandă adoptarea acestor obiceiuri pentru a întări sistemul imunitar și a calma inflamațiile. Acordați prioritate somnului Somnul de calitate permite corpului să se odihnească și să se refacă. Studiile documentează legătura puternică dintre somn și sistemul imunitar în formă maximă. „Noaptea este de obicei un moment de refacere și regenerare pentru piele”, spune Marisa Garshick, medic dermatolog certificat. Academia Americană de Medicină a Somnului recomandă șapte sau mai multe ore pentru adulți. Reduceți consumul de alcool Pe măsură ce îmbătrânim, nu mai metabolizăm alcoolul la fel de ușor. Asta ne afectează calitatea somnului. „Alcoolul este un stimulent, așa că ne trezește, adesea în jurul orei 3 dimineața”, spune Keri Peterson, medic specialist în medicină internă. Dr. Peterson recomandă printre oibiceiuri renunțarea completă la alcool. „Chiar și cu un singur pahar, somnul va fi perturbat”, spune ea. Stabiliți o rutină de antrenament de forță Femeile încep să piardă masa musculară încă de la 30 de ani. Pierdem aproximativ 3-5% pe deceniu. Puteți păstra masa musculară prin ridicarea greutăților câteva zile pe săptămână. „Există o mulțime de cercetări care arată că doar două zile pe săptămână de antrenament de forță oferă efecte pozitive”, spune Kristen McParland, antrenor personal certificat NASM. Beneficiile includ sistem imunitar mai puternic, masă musculară, densitate osoasă, stare de spirit mai bună, somn și sănătate a inimii. Susțineți-vă mușchii cu proteine „Nu contează cât de mult vă antrenați la sală dacă nu aveți un aport adecvat de proteine și carbohidrați”, spune McParland. Doza zilnică recomandată de proteine a fost mult timp de 0,36 grame pe kilogram. McParland recomandă să se vizeze 0,8-1 gram pe kilogram pentru a susține dezvoltarea musculară. Nu uitați de cardio Inima este un mușchi și are nevoie de exerciții. Studiul Stanford menționează că îmbătrânirea a fost asociată cu bolile cardiovasculare. Printre obiceiuri, ghidul de activitate fizică pentru americani recomandă minim 150 de minute pe săptămână de activitate aerobică moderată. „Ar trebui să simțiți că ritmul cardiac crește, poate că sunteți puțin fără suflu, dar puteți totuși să țineți o conversație scurtă”, spune McParland. Aceasta poate fi mers în pantă, ciclism, drumeții sau alergare ușoară. Protejați-vă pielea cu SPF Dacă nu folosiți deja zilnic protecție solară pe față, gât, piept și mâini, acum este momentul, spune dr. Garshick. Razele UV provoacă îmbătrânirea celulelor pielii și pot dăuna ADN-ului celulelor. Există și un risc crescut de cancer de piele. Crema de protecție solară trebuie să aibă factor de protecție solară de cel puțin 30. Trebuie să fiemarcată ca „spectru larg”, pentru protecție împotriva razelor UVA și UVB. Obiceiuri suplimentare după 50 de ani Dacă faceți deja toate cele de mai sus, iată măsuri suplimentare recomandate de experți. Discutați despre terapia de substituție hormonală În timpul perimenopauzei și menopauzei, nivelurile de estrogen și progesteron scad. Acest lucru provoacă bufeuri, creștere în greutate, tulburări de somn și multe altele. „Recomand femeilor să discute cu medicul lor despre avantajele și dezavantajele tratamentului”, spune dr. Peterson. Tratamentul cu estrogen și progesteron va ajuta la ameliorarea bufeurilor, transpirațiilor nocturne, uscăciunii vaginale și prevenirii osteoporozei. Mențineți creierul stimulat și ager Majoritatea persoanelor vor experimenta o formă de declin cognitiv până la vârsta de 70 de ani. Studiul Stanford menționează că boli precum Parkinson și Alzheimer au puncte de cotitură în jurul vârstei de 40 și 65 de ani, notează Womens Healthmag. Dr. Peterson recomandă stimularea creierului prin activități precum hobby-uri, lectură și cuvinte încrucișate. „Dacă vor să îmbătrânească în aceeași stare în care se află acum, trebuie să-și stimuleze creierul”, spune ea. Ea recomandă și jurnalul de recunoștință pentru sănătatea mentală. „Pentru unele persoane, este o perioadă în care observ o ușoară creștere a depresiei”, spune ea. Adăugați exerciții de flexibilitate și echilibru Dacă antrenamentul de forță nu include deja exerciții de flexibilitate și echilibru, acum este momentul. „Începi să devii mai rigid, mai încordat”, spune dr. Peterson. „De obicei, recomand mult mai multe exerciții de stretching și echilibru pe măsură ce pacienții se apropie de 60 de ani”. Exercițiile de echilibru pot fi mersul în linie dreaptă, starea pe un picior cu ochii închiși sau coborârea scărilor fără balustradă. Considerați antrenamentul dinamic Dacă rutina include deja forță, cardio, flexibilitate și echilibru, McParland sugerează antrenamentele dinamice. Acestea vor ajuta la timpi de reacție mai buni în cazul unei împiedicări și poate preveni o cădere. „Nu trebuie să fie neapărat sărituri, deoarece acestea pot fi intimidante”, spune ea. Poate fi vorba de kettlebell swings sau exerciții în care vă ridicați pe vârfuri și coborâți rapid. „Nu este niciodată prea târziu”, subliniază McParland. „Lucrez cu clienți în vârstă de 60 de ani care observă schimbări cu adevărat pozitive”.
Experții europeni sprijină România la proiectele cu finanțare SAFE

O nouă întâlnire de lucru pentru pregătirea proiectelor propuse de România pentru a fi finanțate prin mecanismul european Security Action for Europe (SAFE) a avut loc miercuri la Palatul Victoria, anunță Guvernul. La consultările coordonate de șeful Cancelariei Prim-Ministrului, Mihai Jurca, au participat experți ai Comisiei Europene și reprezentanți ai ministerelor și instituțiilor implicate în pregătirea portofoliului național de proiecte. România va beneficia de un împrumut în valoare de 16,68 miliarde de euro, fiind a doua țară din UE din perspectiva sumelor disponibilizate prin Programul SAFE. Discuțiile au fost urmate de două vizite. Primul obiectiv vizitat a fost Uzina Mecanică București, unde se produc transportoarele blindate Piranha, având în vedere că, la această uzină, România își propune să dezvolte un proiect prin Programul SAFE, se arată într-un comunicat de presă al Guvernului. Al doilea obiectiv vizitat a fost baza aeriană a Ministerului Afacerilor Interne, unde se regăsesc toate elementele cu utilizare civilă și militară pe care forțele de ordine publică le au în dotare. ”Sprijinul Comisiei Europene este extrem de important pentru a definitiva lista de proiecte a României, precum și achizițiile comune cu alte state, interoperabilitatea și reducerea timpilor de livrare, prin creșterea capacităților de producție. Ne focusăm atenția asupra dezvoltării industriei românești de apărare și integrării în lanțurile valorice din Europa. De asemenea, interesul nostru este legat de realizarea sectoarelor de autostradă Pașcani-Ungheni – Pașcani-Siret, precum și de creșterea capabilităților militare și civile de apărare. Mulțumesc instituțiilor care participă activ la efortul susținut pentru finalizarea propunerii României în cadrul SAFE și reprezentanților Comisiei Europene pentru sprijinul logistic și administrativ”, a afirmat șeful Cancelariei Prim-Ministrului, Mihai Jurca. Programul SAFE Prin intermediul Programului SAFE, România are ca obiectiv să doteze cu echipamente militare și de utilizare duală toate structurile care au responsabilități în domeniul securității naționale și de apărare civilă. Un alt obiectiv este integrarea industriei naționale de apărare în lanțurile valorice din Europa. De asemenea, prioritară pentru achizițiile susținute prin acest program va fi localizarea producției în România și introducerea companiilor din țară în lanțurile de aprovizionare ale industriei de apărare din Europa. O altă direcție importantă este dezvoltarea de capabilități din categoria dronelor (aeriene sau maritime) în parteneriat cu Ucraina, prin capabilități de producție în România. Cooperarea cu Ucraina, a căror expertiză în acest domeniu este extrem de valoroasă, și cu tot Flancul Estic, din Finlanda până în Bulgaria, este obligatorie pentru a crea un sistem de detecție și a crea un zid de apărare împotriva dronelor. Reprezentanții Comisiei vor susține propunerea României de a deschide dialogul cu restul țărilor de pe Flancul Estic în scopul coordonării capabilităților de detecție și interceptare a dronelor care intră în spațiul aerian suveran, astfel încât să funcționeze ca un mecanism unitar și să fie prima linie de detecție pentru restul Europei. Întâlnirea de la Palatul Victoria La întâlnirea de la Palatul Victoria au participat Directorul General Adjunct în DG DEFIS, coordonator SAFE Herald Ruijters, Fabio Liberti – Director Adjunct Direcția de implementare SAFE, Marta Sadel – Policy officer, Direcția de implementare SAFE, Alina Elena Manea – Policy officer, Direcția de implementare SAFE. Din partea română au participat șeful Cancelariei Prim-Ministrului, Mihai Jurca, ministrul Economiei, Radu Miruță, reprezentanți ai Ministerului Apărării Naționale, Ministerului Afacerilor Interne, Ministerul Transporturilor, Ministerului Justiției și ai structurilor naționale de securitate. Instrumentul SAFE (Security Action for Europe) este un mecanism financiar temporar al Uniunii Europene, cu un buget de 150 de miliarde euro, sub formă de împrumuturi. 19 state membre, inclusiv România, au exprimat interesul pentru acest instrument. Împrumuturile sunt acordate în baza unui plan național de investiții în industria de apărare, aprobat de Comisia Europeană, iar fondurile pot fi utilizate până la data de 31 decembrie 2030.
Experții trag un semnal de alarmă: o ciupercă patogenă ar putea ucide milioane de oameni
O criză fungică în creștere Oamenii de știință trag un semnal de alarmă, pe măsură ce Aspergillus – un tip de mucegai comun, dar potențial letal – se extinde la nivel global, pe fondul schimbărilor climatice, anunță Daily Mail. Deși nu reprezintă în mod normal un pericol în mediul înconjurător, sporii inhalați pot cauza aspergiloză, o infecție severă care afectează plămânii și se poate răspândi la organe vitale. Persoanele vulnerabile, cum ar fi cele cu astm, diabet sau sisteme imunitare slăbite, sunt cele mai expuse riscului. Mai grav pe fondul încălzirii globale Pe măsură ce temperaturile globale cresc, ciupercile precum Aspergillus fumigatus se adaptează la temperatura corpului uman și își extind aria geografică în Europa, Asia și Americi. Cercetătorii estimează că, în următorii 75 de ani, acești agenți patogeni ar putea ajunge până în Arctica, punând în pericol alte aproximativ 9 milioane de oameni. Anumite tulpini, precum Aspergillus flavus, produc toxine cancerigene, al căror ritm de generare este accelerat de temperaturi și niveluri ridicate de CO₂. Rezistență și amenințarea super-ciupercilor Utilizarea intensă a medicamentelor antifungice în medicină și agricultură a dus la apariția „super-ciupercilor” rezistente la tratamente. Aceste tulpini evoluează rapid și pot supraviețui chiar și dozelor mari de medicamente, reprezentând o provocare majoră pentru sănătatea publică. Un focar din 2021, în rândul pacienților cu COVID-19 din unele secții ATI, a evidențiat potențialul lor letal, cu o rată de mortalitate de până la 70%. Subevaluate și subfinanțate În ciuda gravității situației, cercetarea în domeniul infecțiilor fungice rămâne sever subfinanțată – doar o mică parte dintre speciile de ciuperci patogene au fost identificate. Oamenii de știință subliniază necesitatea unor sisteme mai bune de monitorizare, modelare și conștientizare publică pentru a preveni o criză globală de sănătate.
